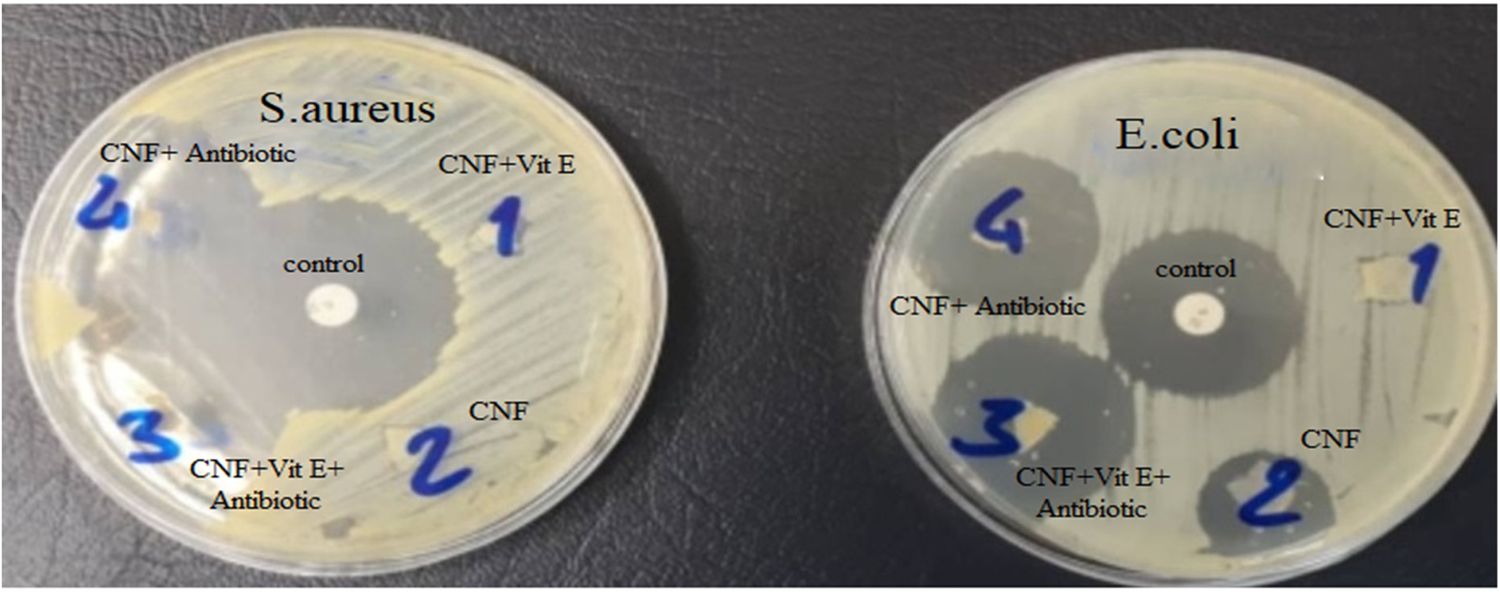
Fig. 10

Fig. 10

The antibacterial inhibition area of CNF, CNF + Vit E, CNF + Antibiotic, and CNF + Vit E Antibiotic, and penicillin (positive control).
The antibacterial inhibition area of CNF, CNF + Vit E, CNF + Antibiotic, and CNF + Vit E Antibiotic, and penicillin (positive control).